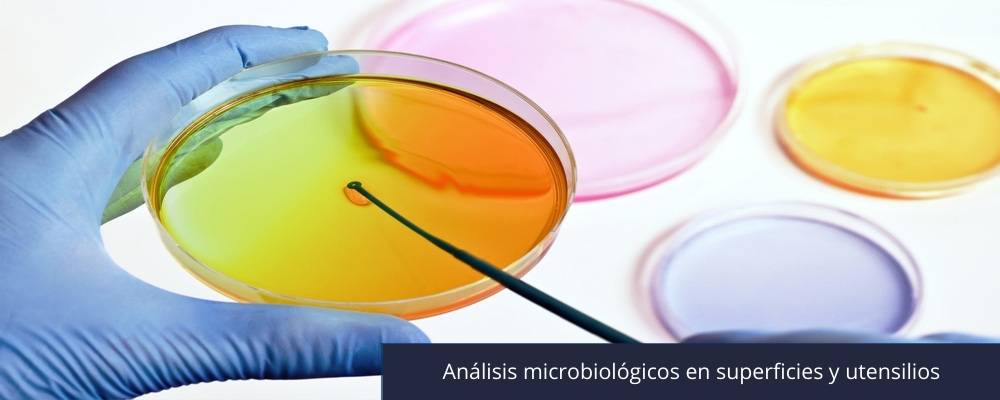
3 Análisis microbiológicos en superficies y utensilios

La validación de los procedimientos de limpieza y desinfección es un requisito crítico para prevenir la contaminación cruzada en la industria alimentaria, farmacéutica y de salud. En Certilab, bajo una dirección técnica de primer nivel, realizamos análisis microbiológicos exhaustivos en superficies, equipos y utensilios, proporcionando la evidencia científica necesaria para asegurar que sus ambientes de proceso cumplan con los más altos estándares de inocuidad y normativa legal.

Análisis Microbiológicos en Superficies y Utensilios:
Garantía de Higiene y Seguridad Procesal
Validación de higiene industrial, muestreo de superficies alimentos, control de Listeria en plantas, análisis de manos manipuladores.
Verificación de Planes de Higiene (HACCP y POS)
El control de superficies no es solo una medida preventiva, es una exigencia técnica para el cumplimiento de los Programas de Operación Estándar de Sanitización (POS) y los sistemas HACCP.
Nuestras metodologías de muestreo
-
- Superficies Vivas (Manipuladores): Evaluación microbiológica de manos de operarios para detectar indicadores de higiene como Enterobacterias y Staphylococcus aureus, fundamentales para validar las buenas prácticas de manufactura (BPM).
- Superficies Inertes (Equipos y Utensilios): Muestreo por técnica de tarrina de contacto o tórulas en líneas de proceso, cintas transportadoras, cuchillos y mesones de acero inoxidable.
- Detección de Biofilms: Identificación de acumulaciones bacterianas resistentes que pueden actuar como focos de contaminación persistente en la planta.
Parámetros Analíticos y Patógenos de Control
En Certilab, aplicamos técnicas de precisión para el recuento e identificación de microorganismos que comprometen la inocuidad:
-
- Recuento de Aerobios Mesófilos: Indicador general de la carga microbiana post-sanitización.
- Enterobacterias y Coliformes Totales: Indicadores clave de la eficacia de los procesos de limpieza en superficies de contacto.
- Monitoreo de Listeria monocytogenes: Análisis crítico en ambientes húmedos y zonas de alto riesgo para evitar la contaminación de alimentos listos para el consumo (RTE).
- Mohos y Levaduras: Control ambiental en zonas de envasado y almacenamiento para extender la vida útil del producto final.
Autoridad Técnica y Excelencia en el Servicio de Certilab
La diferencia de trabajar con un laboratorio especializado radica en la confiabilidad de la toma de muestra y la profundidad del informe.
-
- Respaldo de Dirección Técnica reconocida: Nuestros informes cuentan con la firma de especialistas con vasta experiencia en microbiología industrial, lo que otorga una validez superior ante auditorías y fiscalizaciones.
- Cumplimiento Normativo Estricto: Alineamos nuestros servicios con las guías técnicas del Ministerio de Salud (MINSAL) y los estándares internacionales (ISO 18593).
- Interpretación Expertos de Resultados: No solo entregamos números; asesoramos a su equipo de calidad en la interpretación de los límites de aceptabilidad y la mejora de sus protocolos de higiene.
- Rapidez en la Entrega: Entendemos que la liberación de una línea de proceso depende de la rapidez de nuestros resultados, por lo que optimizamos nuestros tiempos internos para su tranquilidad operativa.
Preguntas Frecuentes sobre Control de Superficies
-
- ¿Cuál es la diferencia entre el método de tórula y el de placa de contacto? Explicamos qué técnica es más adecuada según la porosidad y forma de la superficie a evaluar.
- ¿Qué microorganismo es el mejor indicador de una mala sanitización? Abordamos el rol de las Enterobacterias como centinelas de la higiene industrial.
- ¿Cada cuánto tiempo debo validar mis procedimientos de limpieza? Recomendaciones basadas en el análisis de riesgo y la frecuencia de producción según el RSA.


